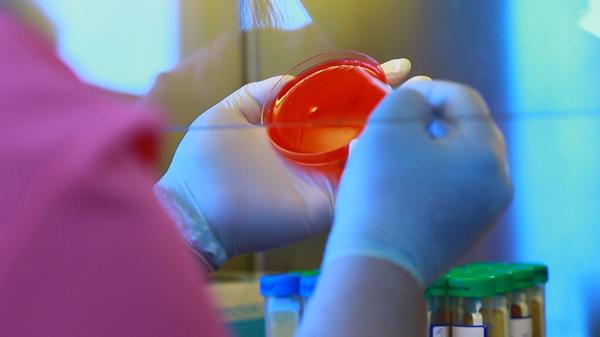
O soluţie perfuzabilă, cauza infecţiei cu piocianic de la Spitalul din Miercurea Ciuc. Ancheta a descoperit că nici instrumentarul nu era sterilizat corespunzător

Știri spitalul miercurea ciuc
Citeste ultimele stiri pe Observator despre Spitalul Miercurea Ciuc. Fii informat cu Observatornews.ro, site de stiri care prezinta cele mai noi informatii, reportaje si evenimente din tara si din lume.
Citeste ultimele stiri pe Observator despre Spitalul Miercurea Ciuc. Fii informat cu Observatornews.ro, site de stiri care prezinta cele mai noi informatii, reportaje si evenimente din tara si din lume.
A fost descoperită cauza infectării cu piocianic a pacienţilor de la Spitalul din Miercurea Ciuc. Bacteria periculoasă provine...
pe 19.01.2022 la 19:55